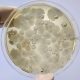
Los bioinsumos se están ganando un lugar en los programas de biostimulación y fitosanitarios

Los bioinsumos se están ganando un lugar en los programas de biostimulación y fitosanitarios
Cerezo, uva de mesa y avellano europeo son tres de los principales cultivos frutícolas en Chile. Redagrícola conversó con tres asesores para conocer cómo está avanzando la adopción de herramientas biológicas en los programas nutricionales y fitosanitarios y qué tan profunda ha sido su recepción en los huertos.
El avance de los productos biológicos ha sido explosivo, y eso ya se nota en los campos de los principales cultivos frutícolas de Chile. Tanto así, que en pocos años no sólo se han colado en los programas de aplicaciones, sino que ya forman parte de programas estandarizados en huertos de cerezos, uva de mesa y avellano europeo.
Lo que aún está en desarrollo, eso sí, es saber qué tan profundo ha avanzado esta ‘revolución biológica’ en los campos ¿Complementariedad o parte clave de los programas? Eso es algo que aún está siendo analizado. Sin embargo, lo que está claro es que los bioinsumos han pasado de un incipiente uso a la masividad en poco tiempo.
Pese a esta explosión de la oferta biológica y su aplicación, los enfoques y usos siempre dependerán de las recomendaciones de cada asesor y qué tan dispuesto esté el productor a adoptar las distintas alternativas, ya sea en bioestimulación o biocontrol.
Los asesores Walter Masman (cerezos), Rodrigo Sapiain (uva de mesa) y Nicolás Manterola (avellano europeo) relatan en las siguientes líneas cómo ha sido el camino que han debido sortear hasta posicionarse, en algunos casos, como una alternativa real, frente a productos convencionales.
EN CEREZOS, UN COMPLEMENTO
“Hoy en día hay una oferta muy importante y muy potente de insumos biológicos, a tal nivel, que mi opinión al respecto es que hay tanta información que nos tendemos un poquito a perder”, sostiene Walter Masman, asesor, especialista en cerezos.

El experto señala que pese a este mar de información, el rápido crecimiento de la oferta de alternativas biológicas, ya sea desde nuevas empresas de investigación hasta titanes de la industria química que han ingresado al negocio, ha permitido que los precios sean competitivos. “Los costos están dentro del rango normal para un programa. Hoy, el hecho de poder utilizar estos productos no generan muchas veces- un aumento de costo frente a lo convencional”, dice.
“Los utilizo de manera complementaria a lo convencional. Soy un convencido que el uso de manera complementaria, cuando se utilizan de buena forma, genera un impacto positivo”, complementa el experto.
Por ello, hace hincapié en la importancia de mantener equilibrios. “Cuando uno se va con un solo formato, por ejemplo, y usamos todo sintético, podría resultar hasta que en algún momento se produce el desbalance. Mientras que, si te vas solo por el lado biológico, puede ser que sea insuficiente el nivel de carga y no se terminará controlando. Por lo tanto, muchas veces necesitamos de ambas alternativas para tener resultados positivos”, argumenta.
Los utilizo de manera complementaria a lo convencional. Soy un convencido que el uso de manera complementaria, cuando se utilizan de buena forma, genera un impacto positivo
Walter Masman.
En sus recomendaciones, apunta a aplicaciones biológicas a nivel de suelo, estimulando las raíces, pero también desde la parte aérea, con aplicaciones de biocontroladores de algunas enfermedades.
En algunos huertos ha realizado ensayos con micorrizas, comprobando que, “desde el punto de vista del estrés del árbol, mejoraba su condición, a través de mediciones de conductancia estomática, de potenciales xilemáticos y de imágenes de NDVI. Vimos que, efectivamente, había un impacto positivo sobre el árbol y, por ende, ya sabemos que los productos sí funcionan”.
Con su grupo de trabajo, ha hecho estudios para comprobar la efectividad de estos productos. “Hay productos que ayudan a mitigar el cáncer bacterial u otros hongos que generan enfermedades de madera. Logran atenuar y mitigar dicho impacto”.
En ese sentido, el asesor señala que los biológicos ya son parte del presente, y que la adaptación y adopción de estos productos por parte de los agricultores es un puente que se está transitando, aunque “es un proceso lento”.
Pero se ha comprobado el impacto positivo que ha tenido el uso de Bacillus subtilis o Trichoderma, “logrando efectos notorios para que las enfermedades no sigan avanzando”, dice y añade que, “hoy, el mismo productor es el que pide aplicar esos bioproductos”, debido a los resultados obtenidos y al ‘boca a boca’ que se comenta entre colegas.

Tal ha sido el éxito, que el asesor señala que los productos biológicos ya están estandarizados en los programas. “Claro que hay zonas donde, por su predominancia de alguna enfermedad o condición climática, efectivamente te permiten hacer más cosas. Lo mismo a nivel de suelo, donde puede que tengamos que aplicar más productos a nivel de suelo que permitan un mejor desarrollo de las raíces. “Me atrevo a decir que, para el control de enfermedades, hay muchas alternativas”.
Masman detalla que su programa incluye, por ejemplo, biocontroladores para enfermedades, aunque insiste: “No es el único camino, están los químicos, pero existe también esta ala biológica que llegó para quedarse”.
UVA DE MESA, UN NUEVO ESTÁNDAR CERCA DE COSECHA
En el caso de la uva de mesa, los productos biológicos ya son parte del estándar, por lo menos en algunos procesos, de acuerdo a Rodrigo Sapiain, asesor internacional en uva de mesa y con mucha actividad tanto en Chile como en Perú.

El experto señala que a nivel de protección, los bioinsumos enfocados a la protección cuentan con un periodo de control “un poquito más corto, pero sí funcionan bien”, aunque advierte que el precio de algunos aún es una limitante, y cada campaña se lanzan al mercado nuevas alternativas químicas, que muchas veces son más baratas, por lo que algunos productores prefieren ese camino.
Pese a esto, señala que la adopción de estrategias biológicas sigue ganando terreno en el cultivo de vides, y, probablemente el más utilizado y que recomienda, es Bacillus thuringiensis, que ya se incluye en los programas de gran parte de los productores para el control de polilla. “Lo usamos en mis programas, en la última etapa del cultivo, entre pinta y cosecha”, precisa Sapiain.
A medida que se acerca la cosecha, cuando ya se aplicaron los químicos, se salta a los productos biológicos para evitar problemas de residuos. “Esto es pensando principalmente en el caso de los insecticidas. En el caso de los fungicidas, usamos algunos productos biológicos para control de hongos, sobre todo los que tienen que ver con pudrición, como botrytis, penicillium y pudrición ácida”, detalla.
En 2023, que fue un año de abundantes precipitaciones en la zona central de Chile, Sapiain comenta que prefirió usar productos biológicos en el fin de flor para los restos florales y también después de pinta, siempre en conjunto con químicos, alternando ambas líneas de productos.
“Nos pasa aún que es muy difícil hacer un programa exclusivamente con biológicos, sobre todo en la zona central de Chile, cuando el gran problema es botrytis. Esa es la gran limitante”, comenta. Así, más que tirarle todo el peso de la responsabilidad al producto biológico, se utiliza más bien como un ‘acompañante’, que permite mantener una presión de las enfermedades controladas, aunque sin cargarle mucho la mano, sobre todo por las condiciones de lluvias que significaron un aumento en la presión de enfermedades.
¿Qué falta a los biológicos para dar el salto en Chile? Sapiain explica que los productos biológicos podrán tener una posición preponderante cuando el programa sea integral, con una visión de tener las plantas equilibradas nutricionalmente.
Por el momento, señala que en la parte hongos, los biológicos han avanzado mucho para controlar Botrytis, donde poco a poco los biológicos han ganado espacio, algo que también ha ocurrido en Perú.
En Elqui hicimos aplicación de micorrizas en poscosecha, y notamos diferencia con significancia estadística, por ejemplo, para la absorción de algunos nutrientes
Rodrigo Sapiain.
“Yo creo que el desafío actual está en el control de insectos, porque hasta el momento tienden a ser un poquito más caros que los convencionales. Quizás ahí hay una diferencia con Perú, porque para algunas plagas, muchas veces la herramienta primaria de control es un producto biológico. Por ejemplo, algunas larvas de polilla, se controlan con productos que son en base a virus, ampliamente usados en Perú. Son efectivos y se ganaron posicionamiento”, comenta Sapiain.
En términos foliares, en tanto, el asesor señala que su uso se está extendiendo, sobre todo de fungicidas.
Respecto al uso de bioinsumos en el suelo, el experto nuevamente ubica a Perú en la delantera sobre Chile. “Ocupan más bioproductos, como Trichoderma para el control de enfermedades de madera, que se ocupa muchísimo en comparación a Chile se ocupa poco, casi nada”, detalla.
¿Por qué la adopción de biológicos ha sido más rápida en Perú que en Chile? Sapiain comenta que estaría netamente asociado a la problemática de enfermedades de madera en Perú, como el pie negro, que es más agresiva allí que en Chile.
“Al buscar soluciones, se llegó a los biológicos”. Y añade que la tendencia actual es el uso de micorrizas. “Son muy usadas, pero estamos comenzando con alguna aplicación un poco más generalizada. En Elqui hicimos aplicación de micorrizas en poscosecha, y notamos diferencia con significancia estadística, por ejemplo, para la absorción de algunos nutrientes”, explica.
AVELLANOS, MÁS SANITARIO QUE NUTRICIONAL
De la mano de una fuerte presencia de la empresa Ferrero en Chile, así como también una amplia demanda desde Europa, el avellano europeo sigue creciendo en Chile.
Esa expansión que ha mostrado en el país en la última década, ha hecho que en los últimos dos o tres años los productores se hayan acercado a los productos biológicos, incorporando biocontroladores y bioestimulantes, con un especial foco en los consorcios de microorganismos, “que es lo que más ha generado interés”, sostiene Nicolás Manterola, asesor, especialista en avellano europeo.

El experto señala que, en general, “la tendencia en el uso de los biocontroladores va más hacia lo sanitario que lo nutricional, ya que en el avellano aun no hay tanta investigación o aplicación en el área nutricional”, dando cuenta de una situación más cercana al ensayo-error que de aplicaciones basadas en pruebas o estudios enfocadas en el avellano. “Hay una tendencia, algo que se asemeja a ‘una moda’, que es la tendencia a lo sustentable. Todos van a ojos cerrados”, comenta, apuntando a que ese ímpetu también llegó al avellano, a pesar de una falta inicial de estudios, resultados o datos y que, por lo mismo, “no se están usando de la mejor manera estas herramientas”.
En los bioestimulantes, la avalancha de alternativas químicas y biológicas para los productores, tal como mencionaba Walter Masman, han generado confusión en muchos de los productores, de acuerdo a Manterola. “Las herramientas están, lo que falta es cómo lo difundes, o cómo tú capacitas para que se usen estas herramientas de la mejor manera”, comenta.
“Creo que hoy día (en el avellano) hay una confusión general, porque se están aplicando productos y no se está yendo al rendimiento. Entonces no nos estamos enfocando en el punto primordial, que es conocer a la planta y los mecanismos de estas herramientas”, explica, advirtiendo que, a veces, suelen aplicarse por aplicar.
Manterola destaca que actualmente están usando mucho ‘carriers’, que son ácidos carboxílicos o polioles, que son los dos carriers más trabajados que se conocen, y que “funcionan muy bien en la parte foliar, sobre todo cuando estoy iniciando los procesos vegetativos, porque toman los nutrientes y los distribuyen más rápido”.
Destaca también la importancia que han tenido los productos biológicos antiestrés, como los aminoácidos, dadas las condiciones climáticas que se han registrado las pasadas temporadas, con inviernos muy fríos y fuertes vientos.
En términos de biocontrol, Manterola cree que aún no hay herramientas biológicas lo suficientemente eficientes efectivas para controlar insectos como el pulgón, cabrito y chinche; ni tampoco ovicidas, aunque sí ha encontrado efectividad en nemátodos, con los que ha tenido éxito en el control de algunos hongos.
Las herramientas están, lo que falta es cómo lo difundes, o cómo tú capacitas para que se usen estas herramientas de la mejor manera
Nicolás Manterola.
En la parte de los controladores de patógenos del suelo, como las Trichodermas, detalla que se han usado y se han trabajado muy bien, así como los Bacillus y Pseudomonas, “que se han trabajado de manera excelente, al igual que los ribosomas o rizobacter”.
Respecto a si los bioproductos han podido ocupar el lugar de los productos químicos, o incluso reemplazar alguno de ellos, Manterola explica que actualmente se está en un punto de ‘control compartido’, donde se aplican y combinan tanto químicos como bioinsumos en distintos periodos, como una instancia de manejo integrado.
“Por ejemplo, para controlar Xanthomonas, haces un análisis de la situación, un diagnóstico y, dependiendo de cuánta es la presión, yo aplico distintas estrategias. Hay productos de resistencia adquirida (RSA), precursores que son moléculas de estos biocontroladores que se meten a la planta, entran y le provocan una ‘reacción alérgica’ por llamarlo de una forma simple, que activa todos los mecanismos transmisores para poder defenderse”, explica el asesor.
Detalla que se aplican cobres, antibióticos u otros distintos tipos de productos que pueden ser muy efectivos para bajar presiones. Una vez que se concreta la baja, se incorpora algún precursor de RSA (como derivados del quitosano) para rematar con una nueva colonia, una nueva población o consorcio “que son colonizadores agresivos, y en caso que quede algún patógeno, vaya y lo colonice. ¿Por qué? Porque como el patógeno queda débil, este otro lo coloniza, lo ataca y lo erradica rápidamente. Entonces esa es una estrategia agresiva que después se mantiene con el biocontrolador”, sugiere. ¿Ha encarecido el costo del programa el uso de bioinsumos? De acuerdo al asesor, si se logra el objetivo, por kilo producido, es más barato, pero nominalmente hablando, es un poco más caro, aunque alude a que todos los nuevos programas que incluyen bioinsumos apuntan a un objetivo de producir más kilos por hectárea.
“En el caso del avellano estamos ‘semi amarrados’ a usar estas alternativas más orgánicas fregados, porque el mayor comprador es europeo y se rige bajo leyes de la comunidad europea. Si empieza a exigir el uso de este tipo de productos, lo encuentro muy beneficioso, y Ferrero ha hecho un buen trabajo en producir lo más sano posible, siendo amigables con el medio ambiente”, afirma.







